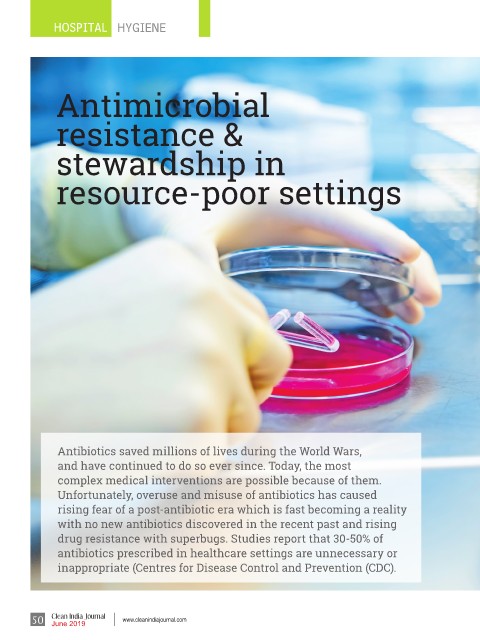

Page 50 - Clean India Journal Magazine June 2019 Issue
P. 50
HOSPITAL HYGIENE
Antimicrobial
resistance &
stewardship in
resource-poor settings
Antibiotics saved millions of lives during the World Wars,
and have continued to do so ever since. Today, the most
complex medical interventions are possible because of them.
Unfortunately, overuse and misuse of antibiotics has caused
rising fear of a post-antibiotic era which is fast becoming a reality
with no new antibiotics discovered in the recent past and rising
drug resistance with superbugs. Studies report that 30-50% of
antibiotics prescribed in healthcare settings are unnecessary or
inappropriate (Centres for Disease Control and Prevention (CDC).
50 Clean India Journal www.cleanindiajournal.com
June 2019